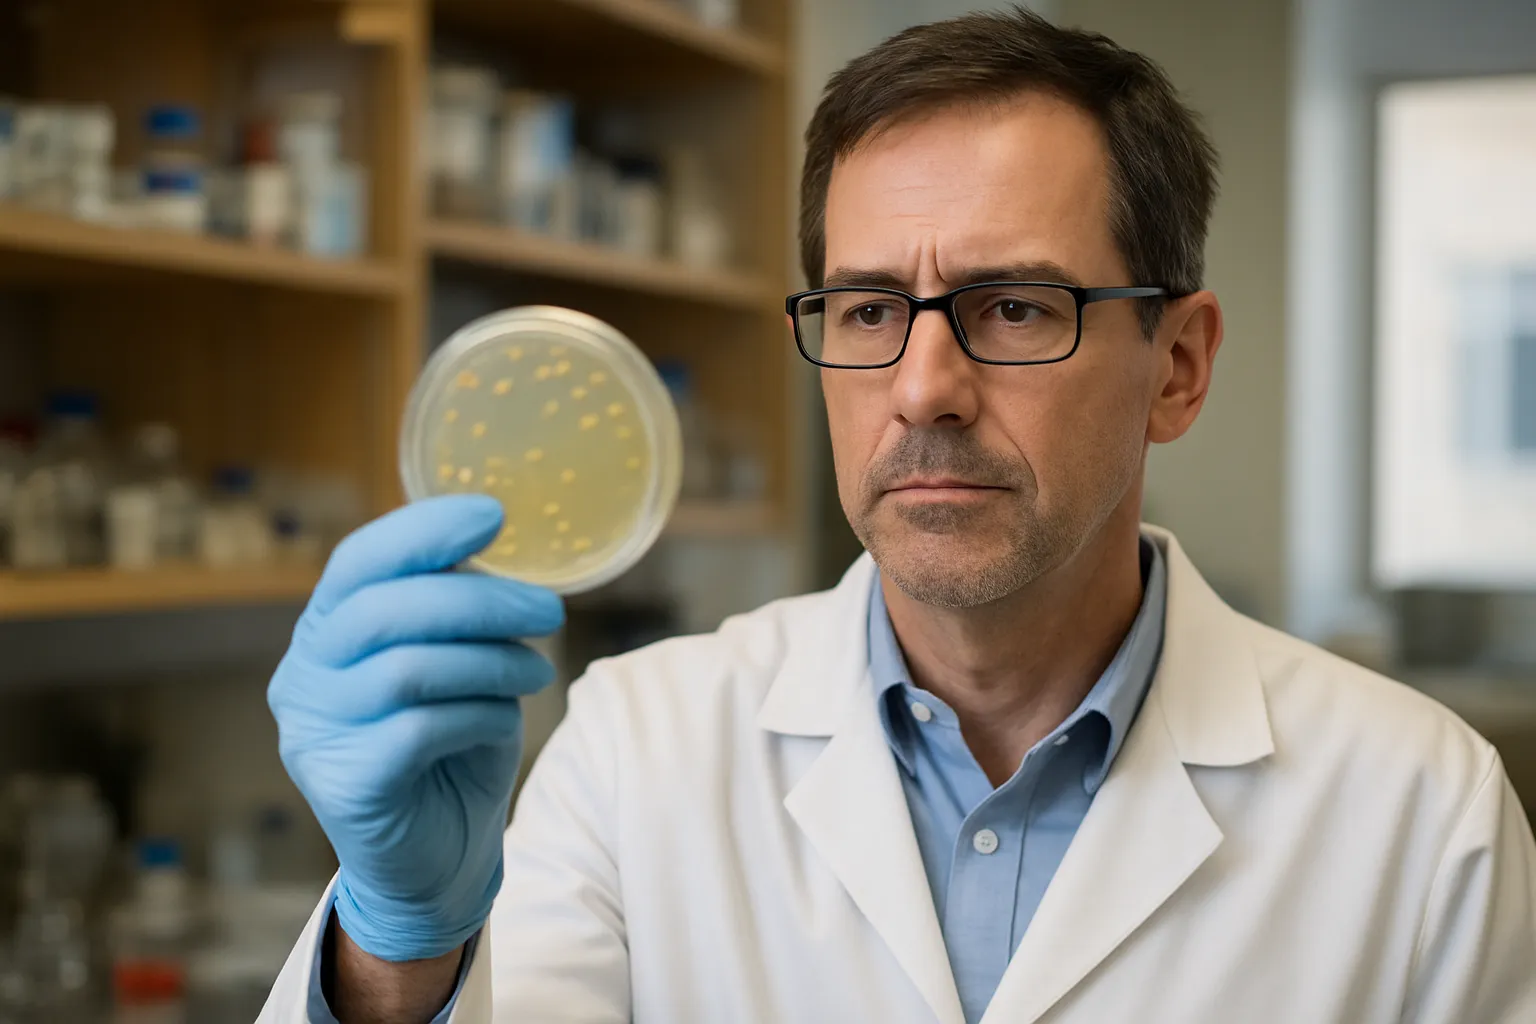
Scientists trace a hidden gut-immune trigger that may help explain ALS and frontotemporal dementia

NIH Unveils a New Strategy for Autoimmune Disease Research-and It Could Change How Studies Get Done
The NIH has launched a new autoimmune disease initiative aimed at coordinating research, improving data and tools, and accelerating progress across conditions that affect tens of millions of...